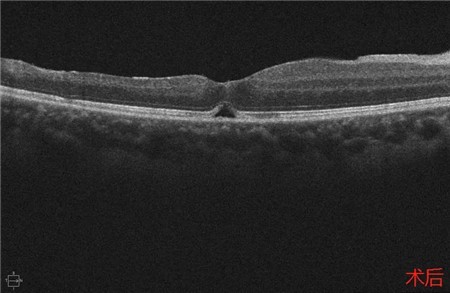

特发性视网膜血管炎、动脉瘤和视神经视网膜炎综合征(Idiopathic Retinal Vasculitis, Aneurysm, and Neuroretinitis syndrome,简称IRVAN综合征)是一种病因不明的较为少见的视网膜血管炎性疾病,此病症常在30-40岁发病且多为女性发病。在发病的前期,如果进行及时有效的治疗干预,预后效果多数较好。但一拖再拖,错过最好的治疗时间,可引起严重的并发症。在这里提醒大家,一定要密切关注自己眼部突发情况的出现,警惕眼前突然发生黑影飘动,视力下降的情况,尽早就医。

经过详细的眼底检查后,患者被诊断为IRVAN综合征引起的右眼黄斑裂孔,张风院长带领医生团队为患者施局右眼玻璃体切除+剥膜+眼内光凝+气液交换手术,经过半个月的恢复,患者右眼术后视力由术前0.3-达到0.6-的状态,且裂孔呈逐渐闭合状态。

关于IRVAN综合征的临床表现
1、症状:
多无症状,有时因玻混眼前黑影就诊,黄斑区受影响时视力下降。
2、体征:
发病前,可先有前葡萄膜炎或玻璃体炎,但多数正常。
视盘附近的动脉和动脉分叉处出现瘤样动脉扩张,视盘充血,边界不清,引起视盘周围视网膜内硬性渗出;视盘周可有少量放射状出血。
静脉不规则扩张和血管鞘膜,周边部小血管广泛闭塞,交界处毛细血管扩张和异常吻合。
严重者可发生从周边到黄斑的血管闭塞和缺血、玻血、新生血管性青光眼,最终视神经萎缩。
长期追踪发现动脉瘤是一种血管炎性的游走性改变,炎症消失时,血管壁强度恢复,瘤体减小,甚至恢复正常。


关于IRVAN综合征的诊断标准

定期的眼部检查必不可少
眼科体检不再是大家心目中的简单的检查视力,很多全身的疾病的早期,都能在眼科有所表现,通过详细的眼底检查可以对这些疾病进行预判。高度近视人群、三高人群、本身伴有自身免疫疾病人群、长期工作压力特别大工作量高负荷的人群、50岁以上的中老年人群,一定要定期做眼部的体检。建议每年至少进行一次眼科的检查,及早的发现眼底病变并积极治疗。
倘若出现眼前突然发生黑影飘动,视力下降的情况,一定要保持警惕,很多突发性的眼部疾病都会有这种症状,请尽快到医院请专业的眼科医生进行诊断和处理。
总之,拥有好的视功能对每一个人来讲,十分宝贵。要定期体检,将危险因素控制在最低,避免视功能的受损。
特别鸣谢:眼底眼综合医生团队张风院长、白华主任、林琳医生提供此病例资料。

|

